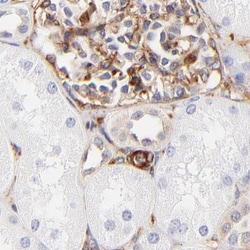
Invitrogen Filamin A Polyclonal Antibody 100 &mu;L; Unconjugated:Antibodies,

Learn More
Invitrogen™ Filamin A Polyclonal Antibody


Rabbit Polyclonal Antibody
Brand: Invitrogen™ PA582043
Description
Immunogen sequence: VICVRFGGEH VPNSPFQVTA LAGDQPSVQP PLRSQQLAPQ YTYAQGGQQT WAPERPLVGV NGLDVTSLRP FDLVIPFTIK KGEITGEVRM PSGKVAQPTI TDNKDGTVTV RYAPSEAGLH EMDIRYDNMH IPGSPLQFYV DYVNCGHVT Highest antigen sequence indentity to the following orthologs: Mouse - 93%, Rat - 92%.
Filamin functions as a crosslinking protein forming a flexible link between two actin filaments. It is composed of two identical polypeptide chains each joined to the other at one end, with an actin binding site at the other. It is present in human platelets, lymphocytes, fibroblasts and smooth muscle actin.
Specifications
| Filamin A | |
| Polyclonal | |
| Unconjugated | |
| Flna | |
| 450 kDa protein; ABP-280; ABPX; actin binding protein 280; actin-binding protein 280; alpha filamin; alpha-filamin; CSBS; CVD1; dilated pupils 2; Dilp2; Endothelial actin-binding protein; Endothelial actin-binding protein 280); F730004A14Rik; filamin; filamin 1; filamin A; filamin A, alpha; filamin, alpha; Filamin1; filamin-1; FilaminA; Filamin-A; FLN; FLN1; Flna; FLN-A; FMD; GENA 379; gizzard filamin; MNS; NHBP; Non-muscle filamin; OPD; OPD1; OPD2; RGD1560614; XLVD; XMVD | |
| Rabbit | |
| Antigen affinity chromatography | |
| RUO | |
| 192176, 2316, 293860 | |
| Store at 4°C short term. For long term storage, store at -20°C, avoiding freeze/thaw cycles. | |
| Liquid |
| Immunohistochemistry (Paraffin), Western Blot, Immunocytochemistry | |
| 0.2 mg/mL | |
| PBS with 40% glycerol and 0.02% sodium azide; pH 7.2 | |
| P21333, Q8BTM8 | |
| Flna | |
| Recombinant protein corresponding to Human FLNA. Recombinant protein control fragment (Product #RP-92135). | |
| 100 μL | |
| Primary | |
| Human, Mouse, Rat | |
| Antibody | |
| IgG |
Your input is important to us. Please complete this form to provide feedback related to the content on this product.